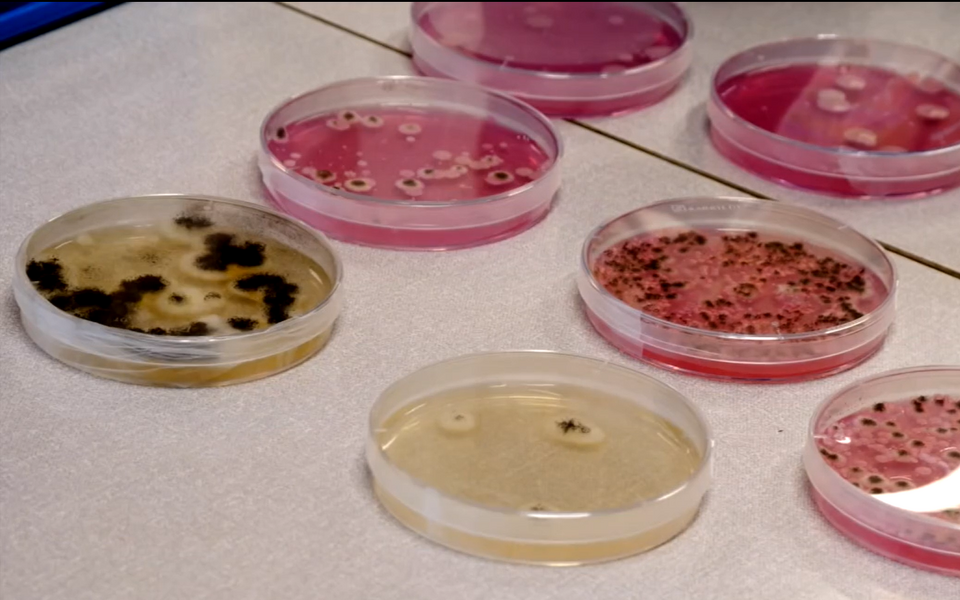
Toidutööstusel tuleb arvestada üha rohkem bakteriga, kes pole varem inimestega ohtu kujutanud ega ebamugavusi tekitanud.

Geograafiaviktoriin: mida tead Eesti haldusjaotuse kohta?

Rahvusvaheline geograafianädal toimub sel aastal 12.–18. novembrini. Tartu ülikooli geograafiatudengite organisatsioon EGEA-Tartu korraldab selle raames kooliõpilastele mõeldud veebiviktoriini.
Viktoriini eesmärk on tutvustada põhikooli- ja gümnaasiumiõpilastele geograafia erinevaid uurimissuundi või rakendusvaldkondi. Nii esitatakse sel nädalal teisipäevast neljapäevani põhikooliõpilastele üks ja gümnaasiumiõpilastele kaks küsimust kas loodusgeograafiast, inimgrograafiast või kartograafiast.
Küsimused ilmuvad iga päev kell 8 EGEA-Tartu veebilehel ja ERR Novaatoris
Vastamiseks on aega samal päeval kella 19.00. Õiged vastused avaldatakse samas koos järgmise päeva küsimusega.
Teisipäevase küsimuse teemaks on inimgeograafia, täpsemalt Eesti haldusjaotus.
Viimasel ajal on palju juttu olnud haldusreformist ning kohalike omavalitsuste (KOV) liitmisest. Milleks meile KOV-id ning kuidas geograafid nendega seotud on?
Eestis on kahte liiki kohalikke omavalitsusi - vallad ja linnad. KOV-id korraldavad kohaliku eluolu: tagavad oma elanikele lasteaia- ja koolihariduse, hoolitsevad sotsiaalhoolekande ja kommunaalteenuste eest ning korraldavad kohalikku kultuuri- ja spordielu. Viimaste kohalike omavalitsuste valimiste järel jõustus haldusreform, mis kahandas KOV-ide arvu 213-lt 79-le. Muutuste taga on eelkõige eesmärk muuta KOV-ide töö efektiivsemaks ning inimeste elu paremaks.
Samadel põhjustel on valdu liidetud varemgi. Vallad tekkisid 19. sajandi alguses, kui Eesti talupojad vabastati pärisorjusest ja tekkis vajadus mõisatest eraldi kohalikku elu korraldada. Paljud väiksed vallad ei tulnud oma ülesannetega toime ning sajandi lõpus toimunud ulatusliku valdade liitumise käigus jäi enam kui tuhandest vallast järgi ligi 350. Vabariigi ajal toimunud reformi tagajärjel kaotati veel ligi 100 valda. Nõukogude võimu ajal saame rääkida hoopis külanõukogudest ja rajoonidest, mis Eesti iseseisvudes taas valdadega asendati.
Saksa geograaf Walter Christaller töötas välja keskuskohtade teooria, mille kohaselt on keskuskohad ehk suuremad linnad ja asulad ümbritsevatele aladele (tagamaale) teenuste pakkujad. Keskuseid ja tagamaid on uuritud ka Eestis - nimelt oli üks esimesi Christalleri teooria rakendajaid Eesti geograaf Edgar Kant 1930. aastatel. Tänapäeval uurivad Tartu Ülikooli geograafid samuti, milliste kohtade vahel inimesed iga päev tööle/kooli - koju liiguvad ehk millised linnad toimivad kui keskused ning kus on nende tagamaa.
Küsimus põhikoolile ja esimene küsimus gümnaasiumile:
Milliste maakondade piirid 2017. aasta haldusreformi käigus ei muutunud?
Õige vastus: Õige vastus on Viljandimaa, Saaremaa ja Hiiumaa. Kõigi teiste maakondade piirid muutusid suuremal või vähemal määral – mitmel juhul vahetasid maakonda terved vallad, kuid mõnel juhul vaid paar küla. Vastuse saab välja lugeda näiteks haldusreformi veebilehel olevalt Rahandusministeeriumi kaardilt või Maalehe interaktiivselt kaardilt hoolega piire jälgides.
Lisaküsimus gümnaasiumile:
Kui võrrelda haldusreformijärgselt eesti kohalikke omavalitsusi, siis milline on pindalt suurim ja milline pindalalt väikseim vald?
Õige vastus: Suurim kohalik omavalitsus on Saaremaa vald (üle 2700 km2), mis hõlmab tervet Saaremaad. Väikseimaks on Loksa linn (3,8 km2), mis jäi ühinemisprotsessist puutumata.
Parimaid vastajaid premeerivad diplomite ja auhindadega Regio ja Petrone Print!
Üritusel saab hoida silma peal ka Facebookis.
Toimetaja: Marju Himma